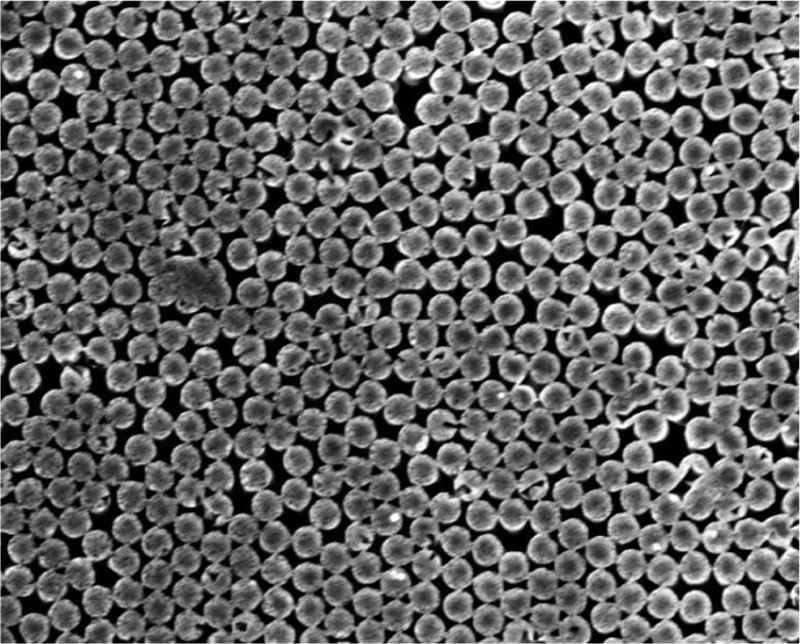

O processo de evaporação da umidade em nosso planeta nunca para, o que torna muito valiosa a ideia de gerar eletricidade por meio desse processo. A água está em toda parte: nos reservatórios, nas plantas e no ar. Resta estudar o processo em todos os seus meandros e utilizar o conhecimento adquirido. Cientistas de Lausanne deram o primeiro passo nessa direção. Eles criaram uma plataforma experimental para estudar “hidrovoltaica”.

Fonte da imagem: SciTechDaily.com
A plataforma consiste em hastes de silício de tamanho nanométrico dispostas verticalmente. Canais são formados entre as hastes através dos quais o líquido, sujeito ao efeito capilar e à evaporação, sobe passivamente à superfície. Na superfície – na interface onde ocorre a evaporação – forma-se uma carga superficial, que fornece condutividade iônica nos canais.
Este método de geração de eletricidade apareceu aos pesquisadores de um ângulo inesperado. Anteriormente, acreditava-se que a energia só poderia ser gerada com água limpa e pré-tratada. Durante os experimentos, descobriu-se que a água pode ter qualquer concentração de sais. Basta expandir os canais à medida que a concentração de sal aumenta e o sistema irá gerar energia. Assim, o processo ocorrerá tanto em água doce quanto em água do mar. O “gerador” pode ser criado sem quaisquer modificações especiais para águas de qualquer salinidade.
Cientistas da Ecole Polytechnique Fédérale de Lausanne (EPFL) alcançaram uma compreensão mais detalhada dos fenômenos e processos físicos modelando e caracterizando fluxos de fluidos, fluxos de íons e efeitos eletrostáticos causados por interações sólido-líquido para, em última análise, criar um dispositivo hidrovoltaico com desempenho ideal.
Vista superior de uma série de nanopilares de silício. Fonte da imagem: Tarique Anwar, LNET EPFL, CC BY SA
«Graças à nossa nova plataforma altamente controlada, este é o primeiro estudo a quantificar estes fenómenos hidrovoltaicos, destacando a importância de várias interações interfaciais. Mas, no processo, também fizemos uma descoberta importante: os dispositivos hidrovoltaicos podem funcionar numa vasta gama de salinidades, o que contradiz o entendimento anterior de que era necessária água altamente purificada para alcançar o melhor desempenho”, afirmam os cientistas.
A solução proposta também pode ajudar na recuperação de calor residual. O calor acelera a evaporação e ajudará a produzir melhor eletricidade. Além disso, o processo de evaporação é frequentemente utilizado para dessalinizar água em climas quentes. No futuro, o processo de dessalinização poderá ser combinado numa instalação com geração de eletricidade. As perspectivas de desenvolvimento são impressionantes, mas ainda precisam ser desenvolvidas.